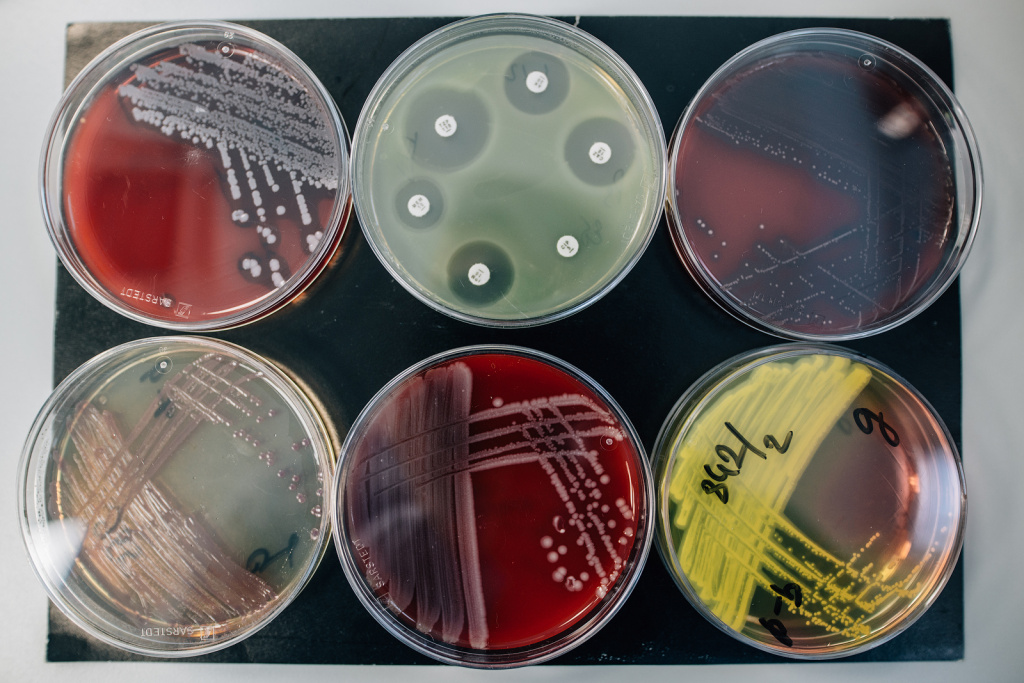

Όνομα Επώνυμο, αλλεργιολόγος ιατρός

- Προσωπικά Στοιχεία: Το όνομά σας, η διεύθυνσή σας, το τηλέφωνό σας και το email σας.
- Στόχος: Μια σύντομη δήλωση σχετικά με τον επαγγελματικό στόχο σας, δηλαδή τον τομέα εργασίας που επιθυμείτε να εξερευνήσετε.
- Εκπαίδευση: Περιγράφετε τις ακαδημαϊκές σας επιτυχίες, όπως πτυχία, μεταπτυχιακά, διδακτορικά, και άλλες εκπαιδευτικές επιτυχίες.


Οι Υπηρεσίες μας
Εδώ θα βρείτε μερικές από τις Υπηρεσίες μας.


Αλλεργικά Τεστ
Τα αλλεργικά τεστ είναι διαθέσιμα για την εντοπισμό των ουσιών που προκαλούν αντιδράσεις στον οργανισμό.


Ρινικές Προκλήσεις
Οι ρινικές προκλήσεις αναφέρονται σε δοκιμασίες που πραγματοποιούνται για τη διάγνωση αλλεργιών που επηρεάζουν το αναπνευστικό σύστημα, συγκεκριμένα τη ρινική περιοχή.


Τροφικές Προκλήσεις
Οι τροφικές προκλήσεις (food challenges) είναι δοκιμασίες που πραγματοποιούνται υπό την επίβλεψη ενός ιατρού ή αλλεργιολόγου για τον προσδιορισμό εάν ένα άτομο έχει αλλεργία σε συγκεκριμένες τροφές.


Ανοσοθεραπεία – Εμβόλια αλεργίας
Η ανοσοθεραπεία, γνωστή και ως υποκείμενη ανοσοθεραπεία (subcutaneous immunotherapy – SCIT) ή ενδογαστρική ανοσοθεραπεία (sublingual immunotherapy – SLIT), καθώς και τα εμβόλια αλλεργίας, είναι μέθοδοι θεραπείας που χρησιμοποιούνται για την αντιμετώπιση των αλλεργικών αντιδράσεων.
Δοκιμασία Μαννιτόλης
Η δοκιμασία με το μαννιτόλη είναι ένα τεστ δερματικής επανάληψης που χρησιμοποιείται στον τομέα της αλλεργιολογίας για τη διάγνωση της αλλεργίας σε συγκεκριμένες ουσίες.

Δοκιμασία – Τεστ Πάγου
Υπάρχουν διάφορες δοκιμασίες που χρησιμοποιούν τον πάγο ή το κρύο για την αξιολόγηση των αντιδράσεων του ασθενούς σε κρύο.

Οφθαλμικές Προκλήσεις
Οι οφθαλμικές προκλήσεις αναφέρονται σε δοκιμασίες που πραγματοποιούνται στον τομέα της οφθαλμολογίας για τη διάγνωση αλλεργιών που επηρεάζουν τα μάτια.

Οφθαλμική αλλεργία
Η οφθαλμική αλλεργία αναφέρεται στην αντίδραση των ματιών σε αλλεργιογόνα, προκαλώντας συμπτώματα όπως κνίδωση, κοκκινίλες, φαγούρα, πρήξιμο και δάκρυα.

Τροφική αλλεργία
Η τροφική αλλεργία είναι μια αντίδραση του ανοσοποιητικού συστήματος σε συγκεκριμένες ουσίες που περιέχονται στα τρόφιμα.

Φαρμακευτική αλλεργία
Η φαρμακευτική αλλεργία είναι η ανεπιθύμητη αντίδραση του ανοσοποιητικού συστήματος σε ένα φάρμακο.

Αλλεργικό άσθμα
Το αλλεργικό άσθμα είναι μια μορφή άσθματος που σχετίζεται με αλλεργικές αντιδράσεις.
Ένα σύγχρονο και τεχνολογικό ιατρείο

Ένα σύγχρονο και τεχνολογικό ιατρείο αλλεργιολόγου θα ενσωματίζει προηγμένες τεχνολογίες και διαδικασίες για τη βελτίωση της ποιότητας της περίθαλψης και την εξυπηρέτηση των ασθενών. Ορισμένα χαρακτηριστικά που μπορεί να περιλαμβάνει ένα τέτοιο ιατρείο περιλαμβάνουν:
-
Ηλεκτρονική Υγειονομική Εγγραφή (ΗΥΕ): Χρησιμοποίηση ηλεκτρονικών συστημάτων για τη διαχείριση των υγειονομικών εγγραφών των ασθενών, προκειμένου να είναι ευκολότερη η πρόσβαση και η κοινοποίηση πληροφοριών.
-
Ηλεκτρονικές Παροχές Υπηρεσιών (ΗΠΥ): Αναπτυγμένα συστήματα προσκόμισης ραντεβού, ειδοποίησης για ιατρικές εξετάσεις, και δυνατότητες online επικοινωνίας για τους ασθενείς.
-
Τηλεϊατρική (Ψηφιακή Ιατρική): Παροχή υπηρεσιών υγείας μέσω διαδικτύου, όπως συνεδριάσεις με τον αλλεργιολόγο μέσω βίντεοκλήσης για συμβουλές και αξιολόγηση συμπτωμάτων.
-
Ψηφιακές Εφαρμογές και Πλατφόρμες: Ενδεχομένως, η ανάπτυξη ή η χρήση ψηφιακών εφαρμογών για την παρακολούθηση των συμπτωμάτων, τη διατροφή, ή τον προγραμματισμό των ιατρικών εξετάσεων.
-
Εργαλεία Διάγνωσης: Χρήση προηγμένων μεθόδων διάγνωσης, όπως αλλεργιολογικά τεστ, ενδοδερμικές δοκιμασίες, και ανοσοθεραπεία.
-
Εκπαίδευση των Ασθενών: Παροχή εκπαίδευσης στους ασθενείς για την αλλεργία τους, τους παράγοντες εκτόξευσης, και τις διαθέσιμες θεραπείες.
Οι παραπάνω παράγοντες συμβάλλουν στη βελτίωση της εμπειρίας του ασθενούς και στην αποτελεσματική διαχείριση των αλλεργιών του.
